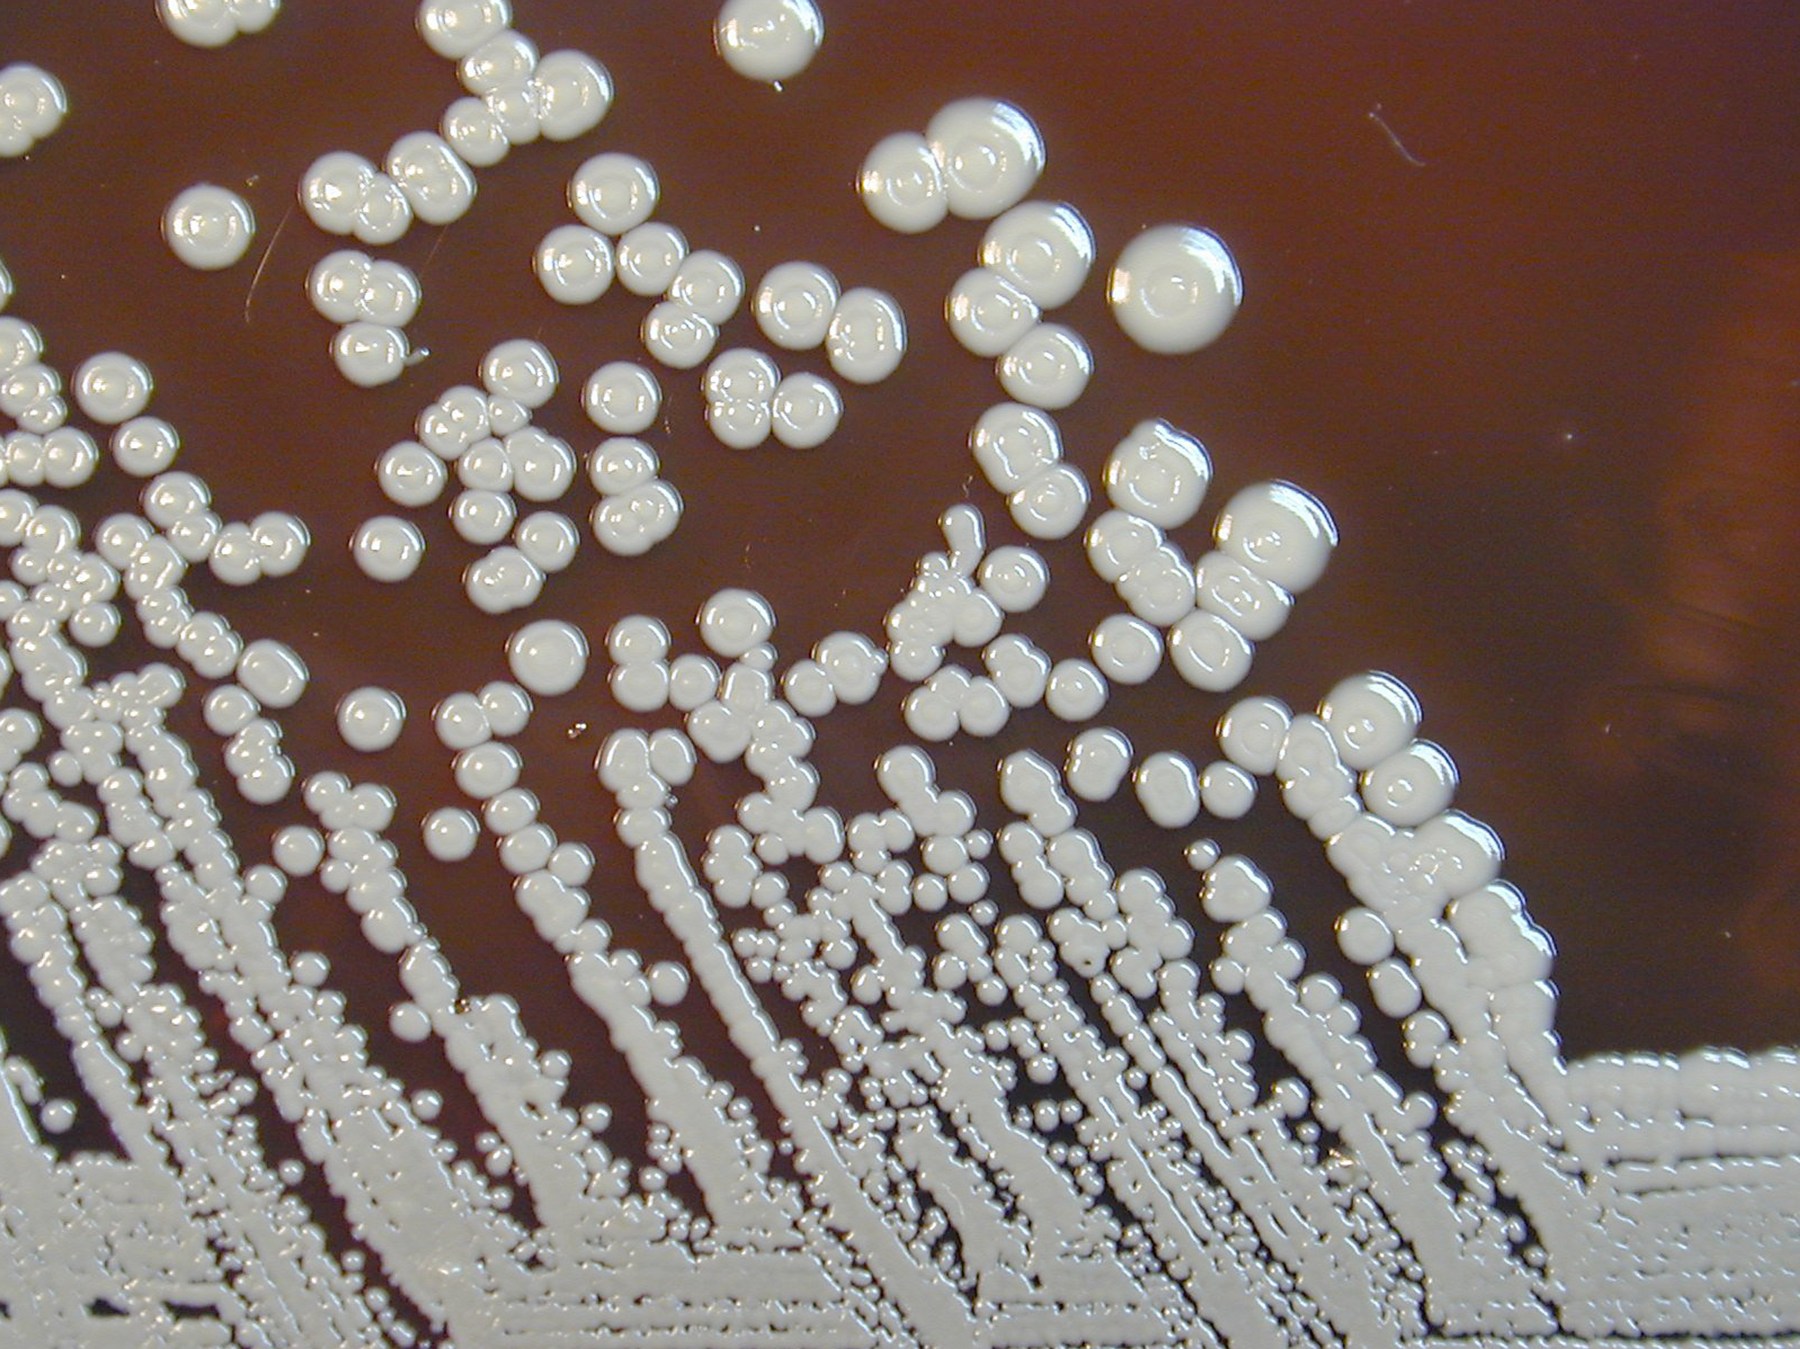

Health officials are heading into shopping centres, markets, pharmacies and clinics across Cairns as melioidosis cases climb sharply this wet season.
Eight people have been diagnosed since January, with heavy rain and muddy conditions stirring up the bacteria that lives in soil and surface water. The illness can enter the body through cuts or be inhaled in fine droplets during downpours.
Cairns Hospital’s Dr Matt O’Bryan is urging anyone over 50 or living with chronic health conditions to take extra care, saying early recognition is critical when symptoms strike suddenly.
The outreach is part of the Cairns and Hinterland Hospital and Health Service’s “Stay Safe from Melio” campaign, which is rolling out across the region to meet people where they are and share practical prevention advice.
Health authorities say people with diabetes, chronic lung disease, kidney issues or weakened immune systems are most at risk. Simple steps like covering cuts with waterproof dressings, wearing sturdy boots in muddy areas and washing exposed skin after contact with soil or water can help reduce the chance of infection.
More information about melioidosis is available via 13 HEALTH or the Queensland Health website.